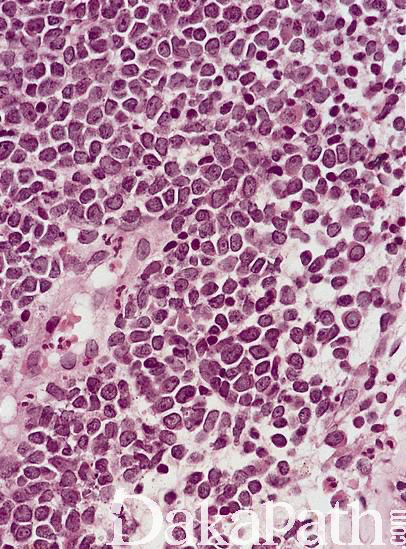

睾丸髓系肉瘤
Testicular Myeloid Sarcoma
发病部位: 睾丸
诊断要点:
- 罕见,可发生于具髓系白血病、骨髓增生异常综合征病史患者,睾丸很少为首发部位,单侧或双侧受累;
- 肿瘤细胞表现为弥漫性生长,或生精精管间浸润性生长,偶尔可浸润至生精小管内,间质可见不成熟的嗜酸性粒细胞浸润,有时伴明显硬化;
- 细胞形态学与免疫表型同急性髓系白血病。
免疫组织化学染色:
表达溶菌酶,MPO,CD34,CD117
鉴别诊断:
恶性淋巴瘤:瘤细胞核形态更不规则,无颗粒状胞浆,免疫组化染色不表达 MPO 而表达淋巴细胞相关的标志物
预后:
差
治疗:
睾丸切除伴术后辅助治疗
病例报道:
Testicularmyeloid sarcoma:casereport.
参考文献:
Clinicopathological, Cytogenetic, and Prognostic Analysis of 131 Myeloid Sarcoma Patients.
Kawamoto K, Miyoshi H, Yoshida N, Takizawa J, Sone H, Ohshima K.
Am J Surg Pathol. 2016 Nov;40(11):1473-1483. Testicular** myeloid sarcoma : an unusual presentation of infant acute myeloid leukemia.
Fonseca A, Scheinemann K, Jansen J, Barr R.
J Pediatr Hematol Oncol. 2014 Apr;36(3):e155-7. doi: 10.1097/MPH.0000000000000097. PMID: 24390442